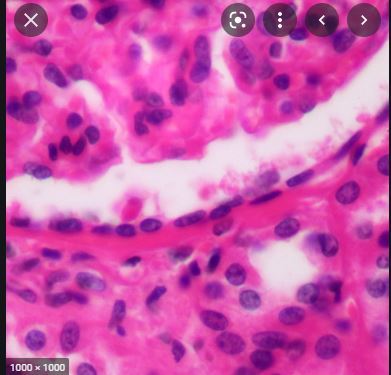

Resolution
ability of microscope to distinguish detail
Histology
Study of tissues and their microscopic structures
What are the 4 basic types of tissues found in human body?
Epithelial tissue, connective tissue, muscle tissue, nervous tissue
Epithelial tissue
Covers boyd surfaces and lines body cavities, hollow organs and ducts of glands.
- Tightly packed together
- Attached to underlying tissues. Attachement is accomplished by basement membrane,
What is the basement membrane?

A thin extracellular structure consisting of 2 layers, basal lamina and reticular lamina
Basal surface

The side of the epithelial tissue that faces the basement membrane
Apical surface

The side of the epithelial tissue that faces the body cavity, lumen or environment
What are the 3 shapes of epithelial cells in body?
Squamous, cuboidal and columnar
Simple epithelium
Single layer of cells in which every cell touches the basment membrane
Stratified epithelium

multiple layers of cells
Name the tissue
how many layers & Shape
Function
Where is it found
Simple squamous epithelium
single layer of thin flat cells - allows for a large amount of transport including flitration, diffusion, secretion and osmosis.
Found in:
Lining of blood vessels and heart
alveoli
glomercular capsule
lining of body cavities
Name the tissue
how many layers & Shape
Function
Where is it found

Simple cuboidal epithelium
Single layer of cuboidal cells. found where secretion and absorbtion occur and provides limited protection
Body location:
Kidney tubules
Thyroid gland
Name the tissue
how many layers & Shape
Function
Where is it found

Simple columnar epithelium
Single layer of cells that are taller than they are wide. Located where secretion and absorption occur. May have microvilli or cilia
Body locations:
Lining of stomach
Lining of small intestine
Lining of large intestine
linging of gallbladder
**Nuclei lined up in same position
Name the tissue
how many layers & Shape
Function
Where is it found

_**Pseudostratified Columnar Epithelium
Contains cells with varying shapes, majority of which are columnar in appearance.**_
Body locations:
**Lining of nasal cavities
Linig of trachea
*goblet cells
**Nuclei NOT centered, LOOKS layers**
Name the tissue
how many layers & Shape
Function
Where is it found

_**Stratified squamous epithelium
Mulitple layers of cells that are squamous at the apical surface.**_
Body Locations:
Epidermis
Lining of rectum
Lining of anus
Lining of vagina
Lining of esophagus
Name the tissue
how many layers & Shape
Function
Where is it found

_**Transitional epithelium
Multiple layers of cells with the apical layer having dome shape appearance**_
Body locations:
Lining of urinary bladder
Linging of Ureters
What are the 3 types of muscle tissue found in the human body?
Skeletal muscle
Cardiac muscle
Smooth muscle
What is the name of the tissue?
What is the shape?
Uni or mulitnucleate?
Striations?
Volunatry or involunatry movment?
Where is it found?

Skeletal Muscle Tissue
Found in skeletal muscles that are attached to the skeleton and can be controlled voluntarily to produce body movement.
Has STRIATIONS. Cylindrically shaped and are MULTINUCLEATE (several nuclei)
BODY LOCATIONS: Skeletal muscles
What is the name of the tissue?
What is the shape?
Uni or mulitnucleate?
Striations?
Volunatry or involunatry movment?
Where is it found?

Smooth muscle tissue
Found in the wall of hollow organs and is involentarily controlled
-Single nucleus per cell and each cell has tappered ends
BODY LOCATION:
Blood vessel wall
Wall of many digestive, urinary and respiratory organs
*Elongated nuclei
What is the name of the tissue?
What is the shape?
Uni or mulitnucleate?
Striations?
Volunatry or involunatry movment?
Where is it found?

Cardiac Muscle Tissue
Cynlindar and branched
Sinle nuclei
Stration and intercalated discs
involuntary movement
Found around the heart
Microvilli

To increase surface area for transport
Found on nonciliaded simple columnar epithelium
cilia

allows substances to be moved across the apical surface
Goblet cells

produce mucus
Intercalated discs

special intercellular connections



